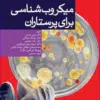
کتاب اصول و مبانی پرستاری پاتروپری 2021 جلد 6 مبانی روانی اجتماعی عملکرد پرستاری

کتاب اصول و مبانی پرستاری پاتروپری 2021 جلد 6 مبانی روانی اجتماعی عملکرد پرستاری
279.000 تومان قیمت اصلی: 279.000 تومان بود.217.620 تومانقیمت فعلی: 217.620 تومان.
-
ناشر جامعهنگر
-
شابک 9786223060359
-
ویراست دهم/2021
-
سال و نوبت چاپاول/1401
-
قطع وزیری
-
نوع جلدشومیز (جلد نرم)
-
تعداد صفحات186
دسته: جامعه نگر
نویسندگان:
پاتریشیاآی پاتر , آن گریفین پری , امی ام.هال

دیدگاهها
هیچ دیدگاهی برای این محصول نوشته نشده است.